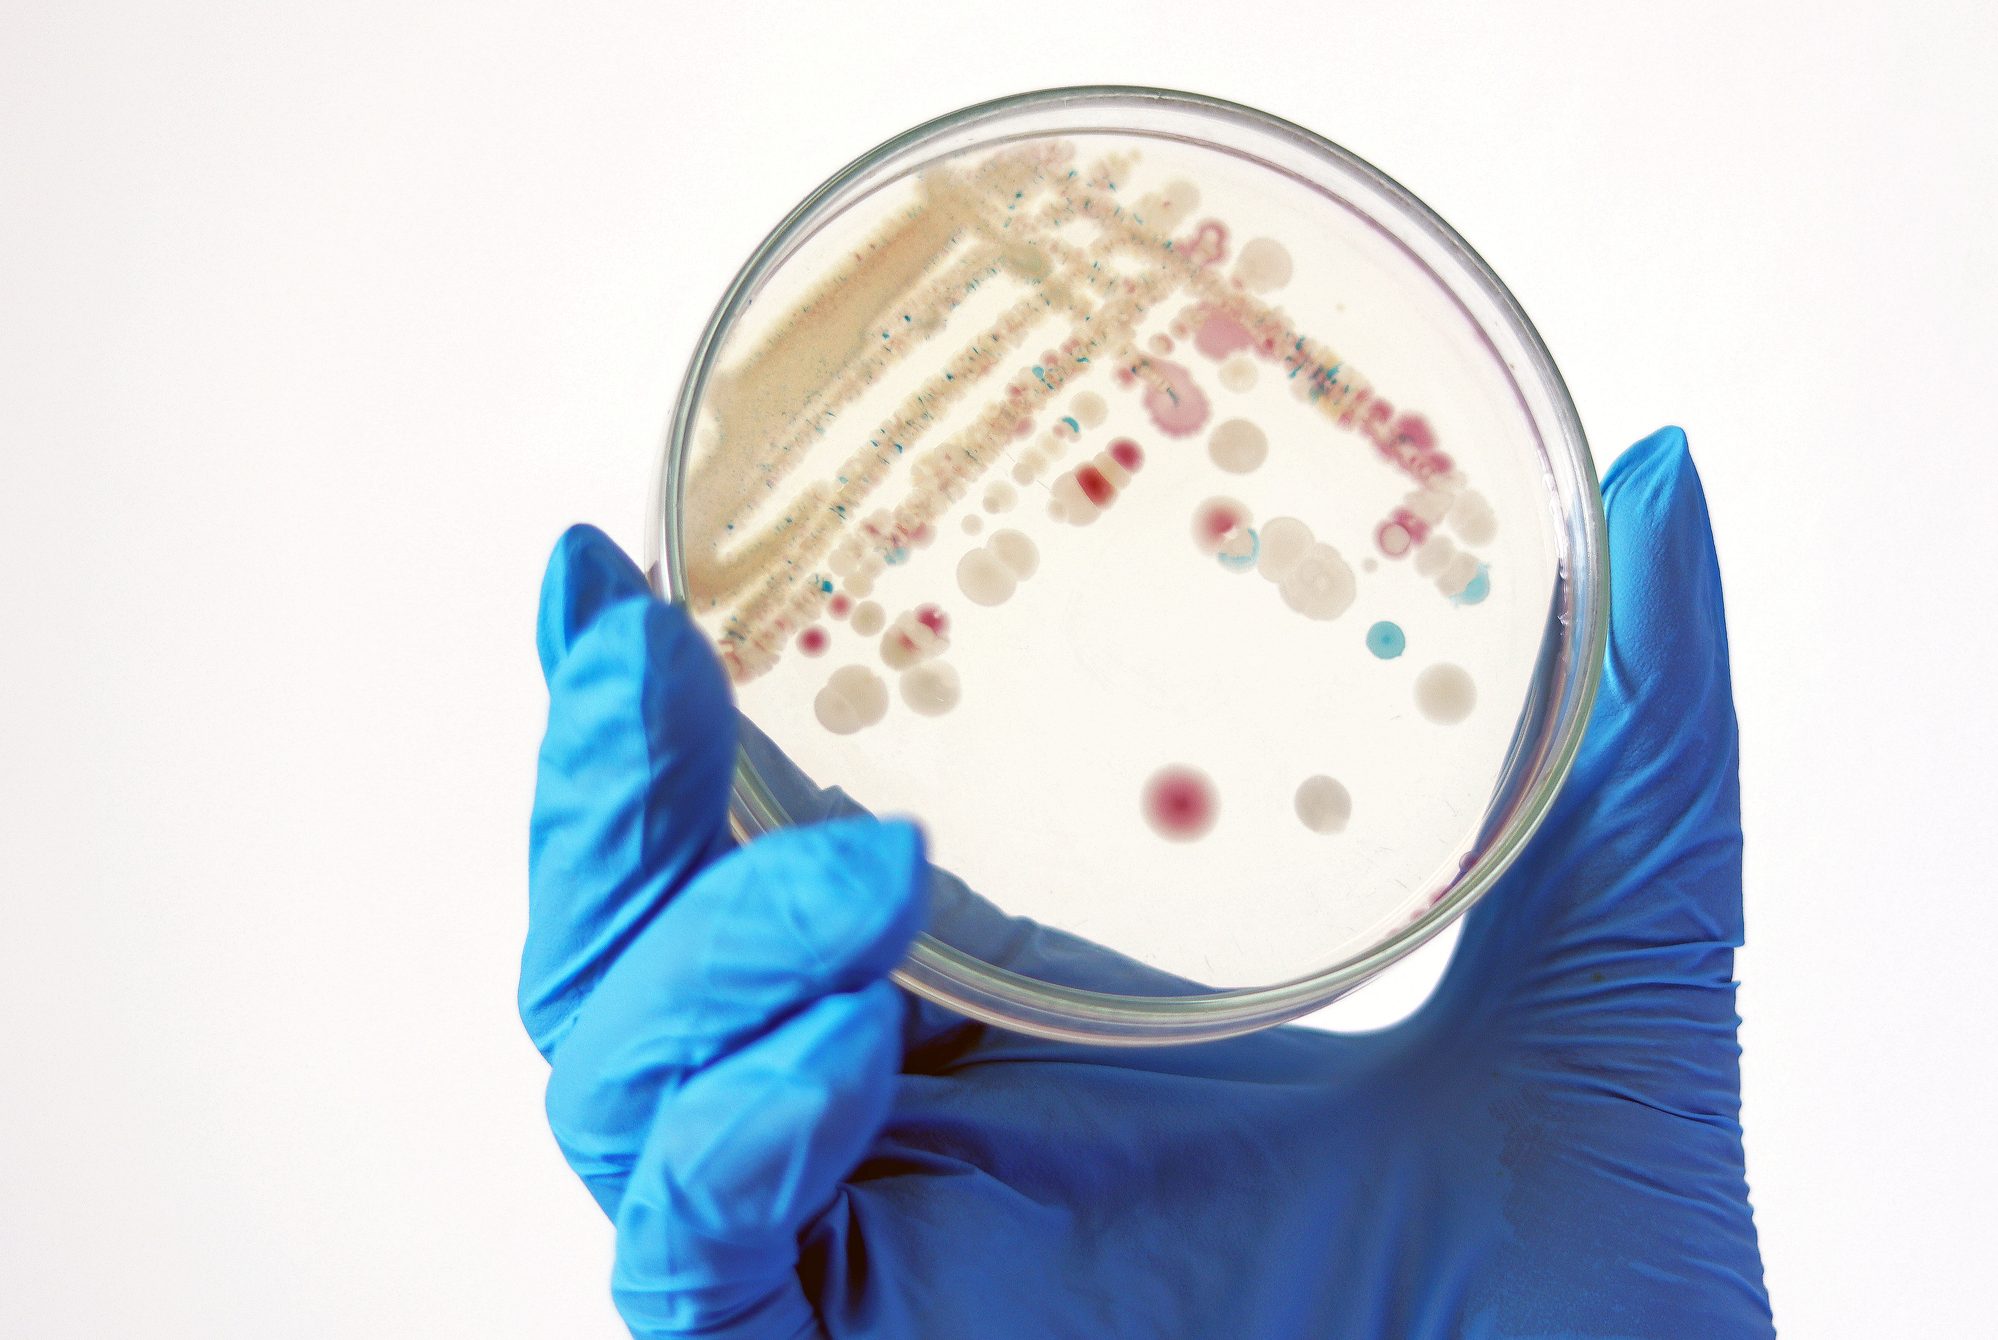
Researcher is holding Petri dish of Vibrio vulnificus in CHROMagar and TCBS, an estuarine bacterium which occurs in in filter-feeding molluscan shellfish, such as oysters., ingestion of the bacterium. (Getty Images)

Vibrio Vulnificus: Flesh-Eating Bacteria Found in South Fork Waters

Vibrio vulnificus, a naturally occurring potentially lethal flesh-eating bacteria, has been found in some East End waters, experts warned about a month before the start of beach season.
Hotspots for the bacteria — which has a 20% chance of death within 48 hours after infection — include Sagaponack Pond, Mecox Bay, and Georgica Pond on the South Fork, Dr. Christopher Gobler, researcher at Stony Brook University and head of the New York State Center for Clean Water Technology, told reporters on April 22. But the discovery “does not necessarily indicate pollution or a widespread public health emergency,” the Southampton Town Trustees said in a statement following the revelation.
“With three fatalities in the past three years, it is a one in 10 million risk,” Gobbler told Dan’s Papers. “Open wounds are a point of entry for the bacteria so covering them or staying out reduces risk.”
The U.S. Centers for Disease Control (CDC) 52,000 to 80,000 cases of Vibrio infection that occur each year are also due to eating raw or undercooked shellfish. The bacteria causes about 100 deaths annually nationwide.
Neither of the affected ponds are designated swimming areas, but the Town of Southampton does operate a bathing beach on Mecox Bay.
“With sensible preventive measures, residents and visitors can continue to safely enjoy the town’s treasured waterfronts throughout the season,” the Southampton Town Trustees said. “Infections are rare, but they can become serious quickly, particularly for people with certain underlying health conditions. Public health officials emphasize that simple precautions can greatly reduce risk while allowing the public to continue enjoying Southampton’s beaches, bays, and waterways responsibly.”
It is advised that immunocompromised and elderly people either stay out of the water, especially if open wounds are present, and wear protection, such as water shoes.
“Immunocompromised are the most vulnerable,” Gobbler added, noting that they are “80x more susceptible to blood infections.”

The CDC lists common signs and symptoms of a Vibrio infection as chills, fever, vomiting, nausea, stomach cramps, and watery bowel movements. Other symptoms CDC lists include low blood pressure, blistering lesions, skin discoloration, and leaking fluids through the skin. Treatments for infection include antibiotics, removal of skin, and in severe cases, amputation.
“The organism is promoted by high temperature, brackish/low salinity water, and an overloading of nitrogen and algae,” Gobler told Dan’s Papers. He previously told reporters that the bacteria was known to only cause issues in the Gulf of Mexico in the 20th century and was not predicted to be in local waters until 2080.
The bacteria thrives on high temperatures, making warmer waters as a result of climate change an issue of concern. The overload of nitrogen in our waterways has been attributed to cesspools and non-functioning septic systems.
Several hypoxic zones, also known as “dead zones” were also found across the island. Hypoxic zones are areas where oxygen has been depleted usually due to runoff of nitrogen and phosphorus. Algae in this area uptake those nutrients, begin to flourish, and block sunlight from the plants below the surface. Once those plants die, they decompose and starve the water of oxygen.
These conditions have been found all around Long Island, including Shinnecock Bay. Parts of Shinnecock Bay have also been closed to shellfishing due to the presence of paralytic shellfish poisoning. There were and are several water quality conditions impacting the east end through 2025 into 2026 such as Vibrio vulnificus, hypoxia, paralytic shellfish poisoning, toxic blue green algae, rust tide, fish kill, and harmful flagellate blooms.
Hope is not lost for the water quality of Long Island. There are technologies already in place to treat this issue. Michael Doall, Associate Director for Bivalve Restoration and Aquaculture at Stony Brook University, said that shellfish and seaweed aquaculture is a possible remedy. Doall explained that these crops undergo “bioextraction” which means they will sequester nitrogen out of the water. Another positive is that they are “zero-input crops” which means they need nothing externally to survive and thrive, they receive everything they need once placed in the water.
There is also work being done on the development end to stop nutrient leaching into the waterways. Deputy Suffolk County Executive Jennifer Jeugnst addressed the media about the Suffolk County Septic Improvement Program (SIP). This is a 35-year program aimed at removing 36,000 non-functioning and outdated cesspools and septic systems. Jeungst stated that homeowners who apply to SIP can get up to $20,000 from Suffolk County to help replace their systems if the project requires it and an additional reimbursement of up to $25,000 from New York State.
Although there is no declared emergency, the public — especially those who have open wounds — is urged to remain cautious and careful when entering waterbodies with low salinity in the area this spring and summer.